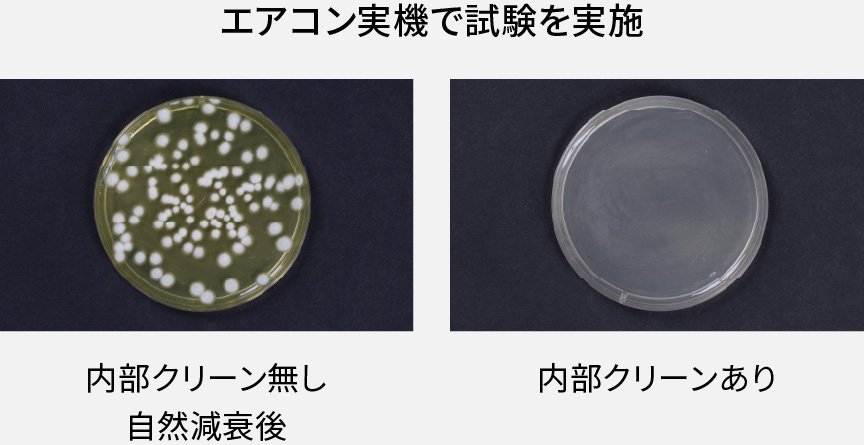
エアコン実機で試験を実施。内部クリーン無し、ありの比較画像です

2025年モデル エオリア 特長清潔・空気清浄(住宅設備モデル)
ご利用区分を教えてください。
お部屋の空気もエアコン内部も清潔
エオリアの清潔性能を動画でチェック
ナノイーX クリーン冷暖


冷暖房しながらナノイーX を放出。
空気中のさまざまな有害物質を抑制*します。


ナノイーXの抑制効果


*:約8畳試験空間での〈カビ菌〉約2時間後※1の抑制効果。約6畳試験空間での〈花粉〉約3時間後、※2〈ニオイ〉約15分後、※3〈PM2.5〉約12時間後、※4〈アレル物質〉約6時間後※5の抑制効果。約6畳密閉試験空間での〈浮遊菌〉約4時間後〈付着菌〉約8時間後、※6〈浮遊ウイルス〉約3.5時間後〈付着ウイルス〉約2時間後※7の抑制効果。数値は実際の使用空間での試験結果ではありません。脱臭効果は、周囲環境(温度・湿度)、運転時間、臭気、繊維の種類によって異なります。
※1:【試験機関】(一財)カケンテストセンター【試験方法】試験室(約8畳)において布に付着させたカビ菌の発育を確認【除菌の方法】ナノイーXを放出【対象】付着したカビ菌【試験結果】約2時間で抑制効果を確認(KT-21-003341-4)。
※2:【試験機関】パナソニック ホールディングス(株)プロダクト解析センター【試験方法】試験室(約6畳)内でELISA法で測定【抑制の方法】ナノイーXを放出【対象】花粉(スギ)【試験結果】約3時間で99%の抑制効果を確認(H21YA017-1)。
※3:【試験機関】パナソニック ホールディングス(株)プロダクト解析センター【試験方法】試験室(約6畳)において6段階臭気強度表示法により検証【脱臭の方法】ナノイーXを放出【対象】疑似体臭(ノネナール)【試験結果】約15分で臭気強度1.9低減(21HM005-1)。
※4:【試験機関】パナソニック ホールディングス(株)プロダクト解析センター【試験方法】試験室(約6畳)で付着した有機物量を測定【抑制の方法】ナノイーXを放出【対象】アルカン:ヘキサデカン【試験結果】約12時間で99%以上分解(H21NF016)。
※5:【試験機関】パナソニック ホールディングス(株)プロダクト解析センター【試験方法】試験室(約6畳)内で電気泳動法またはELISA法による検証【抑制の方法】ナノイーXを放出【対象】アレル物質(ヤケヒョウヒダニ)【試験結果】約6時間で低減効果を確認(H21YA046-1)。
※6:〈浮遊菌〉【試験機関】(一財)北里環境科学センター【試験方法】試験室(約6畳)において菌を浮遊させ空気中の菌数を測定【除菌の方法】ナノイーXを放出【対象】浮遊した菌【試験結果】約4時間で99%以上抑制(北生発2016_0279号)。〈付着菌〉【試験機関】(一財)日本食品分析センター【試験方法】試験室(約6畳)において布に付着させた菌数を測定【除菌の方法】ナノイーXを放出【対象】付着した菌【試験結果】約8時間で99%以上抑制(第13044083003-01号)。(試験はそれぞれ1種類のみの菌で実施)
※7:〈浮遊ウイルス〉【試験機関】(一財)北里環境科学センター【試験方法】試験室(約6畳密閉空間)においてウイルスを浮遊させ空気中のウイルス感染価を測定【抑制の方法】ナノイーXを放出【対象】浮遊したウイルス【試験結果】約3.5時間で99%以上抑制(北生発2021_1659号)。〈付着ウイルス〉【試験機関】ホーチミンパスツール研究所【試験方法】試験室(約6畳密閉空間)においてウイルスを布に付着させウイルス感染価を測定【抑制の方法】ナノイーXを放出【対象】付着したウイルス【試験結果】約2時間で99%以上抑制(Accreditation No. VILAS Med 014)。(試験は1種類のみのウイルスで実施)
ナノイーX 送風
ナノイーXを放出する、送風のみの運転ができます。
冷房や暖房を使わない季節や、花粉が多くなる春先などに。
●消費電力量約12Wh。電力料金めやす単価31円/kWh(税込)[2022年7月改定] で計算。ご使用条件等によって異なります。
においケア モード
気になる空間臭に。※1 ナノイーX放出と室温や状況に適した運転で、効果的に脱臭します。※2
ねらって脱臭
センサーが検知・学習した「人がよく居る場所」をねらってナノイーXを送風。付着したニオイもすばやく脱臭します。※2
●「ねらって脱臭」はあらかじめ設定が必要です。
空間臭

付着臭

※1:【試験機関】パナソニック ホールディングス(株)プロダクト解析センター【試験方法】JIS B 9917参照。当社試験室(約14畳)において、ニオイ成分(酢酸)を散布、インピンジャー法により室内大気をサンプリングし、ICにて分析。自然減衰したものと、温度30℃、湿度75%から「においケア」除湿モード運転をした後の、室内空間中の酢酸濃度を定量化し、比較 【対象】酢酸 【試験結果】自然減衰から52%の濃度低減を確認(M20SK022)。
※2:【試験機関】パナソニック ホールディングス(株)プロダクト解析センター【試験方法】試験室(約6畳)において、付着したニオイ成分(疑似汗臭:ヘキサン酸)を振とう抽出し、GC/MSにて分析を実施。自然減衰したものと、「においケア ねらって脱臭」運転をした後の疑似汗臭成分の濃度を定量化し、比較【対象】付着した疑似汗臭成分【試験結果】30分で自然減衰から74%の濃度低減を確認。(H23HM007-4)
※3:【試験機関】パナソニック ホールディングス(株)プロダクト解析センター【試験方法】試験室(約6畳)において6段階臭気強度表示法により検証【脱臭の方法】においケア ねらって脱臭運転を実施【対象】付着した、疑似汗臭・疑似体臭(ノネナール)・疑似ペット臭【試験結果】〈汗臭〉30分で臭気強度1.1低減(H23HM013-1、H23HM016-1)。〈体臭〉30分で臭気強度1.7低減(H23HM024-2)。〈ペット臭〉30分で臭気強度1.0低減(H23HM023-2)。
ナノイーX 内部クリーン
エアコン内部のカビ菌を自動で除菌します※1*1
●Jシリーズ / Nシリーズはカビ菌を抑制※2*2。下記の効果とは異なります。
運転後に自動で*3 スタート。ナノイーXを内部のすみずみまで充満させ、
清潔をキープします。1回あたりの電気代は約1.7円。※3
*1:生えてしまったカビを除去する機能ではありません。内部クリーン運転の動作内容を「送風自動」に変更した時は、カビの成長を抑制※4 する効果となります。
*2:生えてしまったカビを除去する機能ではありません。※2
*3:30分以上運転を行い、停止した時。長時間連続運転中は内部クリーン運転を行いません。連続運転中に内部クリーン運転をさせたい時はあらかじめ設定が必要です。


エアコン内部のカビ菌を除菌※1 *1

エアコン内部に付着した油分まで分解・低減※5


●冷房時の内部クリーン、暖房時の内部クリーンを1回行い揮発油成分が総量で減じられる効果。設置環境、使用状況により効果は異なります。
油の定着を軽減する事でカビが増えにくい環境に
油の付着を軽減できているということは、カビにとっての栄養素の一つを減らし、
さらに飛来するカビ胞子や、外来からの栄養源を定着しにくくすることにもなるため、
「カビが増えにくい環境になっている」と考えられます。
●パナソニックから向本先生に依頼し、頂いたコメントを編集して掲載しています。


エアコン内部の汚れかたの違い(冷房時の内部クリーン運転)※6
●約1年後。使用頻度や使用環境によりカビやホコリのつき方、ホコリの量は異なります。


※1:【試験機関】(一財)北里環境科学センター【試験方法】室温25℃、湿度70%の試験室(約6畳)にて、エアコン内部にカビ菌を滴下した試験片を設置、1日3時間の冷房運転後に「内部クリーン」運転を動作させ、試験前と4日後のカビ菌の数を比較【試験結果】試験片のカビ菌(1種類)が、「内部クリーン」運転なし(自然減衰後)から99%除去されたことを確認(北生発2021_1202号)。
※2:【試験機関】(一社)カビ予報研究室 【試験方法】室温25℃、湿度70%の試験室(約10畳)にて、エアコン内部にカビセンサーを設置、1日2時間の冷房運転後に内部クリーン運転ありとなしの条件において、4日後のカビの菌糸長を比較 【抑制方法】エアコン内部の加熱と乾燥 【対象】エアコン内部に付着したカビ(2種類)【試験結果】カビの菌糸の成長抑制効果あり(180609)。
※3:消費電力量約54.9Wh。電力料金めやす単価31円/kWh(税込)[2022年7月改定]で計算。ご使用条件によって異なります。
※4:【試験機関】(一社)カビ予報研究室【試験方法】室温25℃、湿度70%の試験室(約6畳)にて、エアコン内部にカビセンサーを設置、1日3時間の冷房運転後に内部クリーン運転ありとなしの条件において、4日後のカビの菌糸長を比較【試験結果】カビセンサー内のすべてのカビ(3種類)で、カビの成長が抑制されることを確認(210701)。
※5:【試験機関】パナソニック ホールディングス㈱プロダクト解析センター【試験方法】油成分を、フィルター、熱交換器、風路の位置に設置、冷房および暖房時の内部クリーンに曝露したものと、曝露していないものとの残留物を抽出し、定量分析を実施【試験結果】冷房時、暖房時とも風路内位置で、9%~74%の低減効果を確認(〈冷房時内部クリーン〉Y19HM008、Y19HM016、H22HM005〈暖房時内部クリーン〉Y19HM017)
※6:当社調べ。【試験方法】揮発油の導入と冷房時の内部クリーンを繰り返したエアコンと、揮発油の導入のみのエアコンに、模擬微塵を曝露し目視により付着量を比較【試験結果】模擬微塵の付着量に差がある事を確認。
フィルターお掃除ロボット
運転後に自動で*フィルターをお掃除。
お手入れの手間も電気のムダも減らします。
ホコリをブラシでかき取り、ダストボックスに吸引。
自動排出方式なら、集めたホコリは自動で*屋外へ排出。
ダストボックス方式でも、約1年に1回捨てるだけです。
さらに、ブラシについたホコリを回収するブラシクリーナーを搭載。
フィルターもブラシも常にキレイを保ちます。
※:GXシリーズはブラシクリーナー非搭載。




●約1年後。使用頻度や使用環境によりカビやホコリのつき方、ホコリの量は異なります。
フィルターお掃除のしくみ


★:国内壁掛け形エアコンにおいて。2024年12月1日現在。(当社調べ)
自動排出方式は、ダストボックス方式に切り換え可能
自動排出しないダストボックス方式に変更できるから、隠ぺい配管にも対応できます。
●ダストボックス方式への切り換えには工事が必要です。お買い上げの販売店へご依頼ください。切り換えた場合は、ボックスに溜まったホコリを捨てる必要があります。
ムダな消費電力量 約25%カット※1(暖房時)
暖房時の消費電力量の割合(約1年後)


お掃除ロボット搭載エアコン 累計販売※2 台数1,000万台を突破
*:累積24時間以上運転後に自動で掃除。ホコリや油汚れが多い環境等でご使用になる時は、取り外して水洗いをする等をおすすめします。
※1:平均室温一定で運転した場合の購入時に対する消費電力量の割合を、フィルターお掃除ロボットありと、フィルターお掃除ロボットなし(フィルターにホコリ約2gが付着した状態)の約1年後で比較。(当社調べ)【試験条件】 CS-405DHX2の場合。当社環境試験室(約14畳)、外気温2℃、設定温度23℃、風量・風向自動、暖房運転安定時。消費電力量の、フィルターお掃除あり(455Wh)と、フィルターお掃除なし(607Wh)との比較。使用頻度や使用環境により効果は異なります。
※2:フィルター自動お掃除ロボット搭載機種2005年1月~2022年3月累計販売台数。
NEW 集中おそうじ
| 対応機種 |
|---|
| HXシリーズ |
ワンボタンで、内部を清潔に保つ機能を一括動作。原因物質(ノナナール)を低減※し、 使い始めのニオイを防止します。
●この機能は電力を消費します。
●運転中は冷たい/暖かい風が出るため、寒い/暑いと感じることがあります。人がいない時のご使用をおすすめします。

ニオイの原因物質(ノナナール)


※:【試験機関】パナソニック ホールディングス(株)プロダクト解析センター【 試験方法】市場を模擬した疑似ホコリにノナナールを付着させ、集中おそうじモードに曝したものと曝していないものとのエアコン吹き出し風の空気の定量分析を実施【 試験結果】集中おそうじモード(137分)により98%低減することを確認。(Y23KI159)
おでかけクリーン
ナノイーX送風、フィルター自動掃除、内部クリーン運転をワンセットで行います。
外出中にお部屋の空気もエアコン内部もきれいにしてくれます。
①「ナノイーX」送風
お部屋の空気を清潔にします
②フィルターお掃除
フィルターのホコリを捕集・排出
●GXシリーズはホコリの自動排出には非対応。
③内部クリーン
内部を加熱乾燥、ナノイーXでカビ菌を抑制※
※:【試験機関】(一社)カビ予報研究室 【試験方法】25㎥(約6畳)、室温25℃、湿度70%の試験室にて、エアコン内部にカビセンサーを設置、1日3時間の冷房運転後に「内部クリーン」「ナノイーX」「カビみはり」「フィルターお掃除」ありとなしの条件において、7日後のカビの菌糸長を比較 【試験結果】カビセンサー内のすべてのカビ(8種類)で発芽はなく、カビの成長が抑制されることを確認(報告書No. 180301、180302)。
ホコリレスコーティング(熱交換器)
熱交換器表面(アルミフィン切断面)までを、独自技術★ でコーティング。
自然発生する水で汚れをつるっと洗浄*します。
カビの栄養源となるホコリの付着を防いで、内部を清潔に保ちます。
*:冷房・除湿運転時




★国内壁掛け形エアコンにおいて。熱交換器のフィン切断面に対し、親水性および、はつ油性の特性を有する、シリカ材によるナノメートルレベルの凹凸表面処理を施したコーティング技術。2024年12月1日現在。(当社調べ)
●使用頻度や使用環境によりカビやホコリのつき方、ホコリの量は異なります。
親水コーティング(熱交換器)
熱交換器全体を、水によくなじむ親水コーティングで加工。
自然発生する水で、ホコリを洗い流します。*
*:冷房・除湿運転時


●油汚れが多い環境等でご使用になる場合は、別途熱交換器の洗浄が必要になる場合があります。
その他の清潔仕様
抗ウイルスエアフィルター
Ag+(銀イオン)に加え、抗ウイルス剤をコーティング。
捕集したホコリに潜む菌の増殖を抑制し、※1 特定ウイルスの数を減少※2 させます。


※1:【試験機関】(一財)ボーケン品質評価機構【試験方法】JIS Z 2801【試験結果】24時間後に99%以上の低減率を確認(試験番号JNLA2022K0729)(試験番号JNLA2022K0832)(試験番号JNLA2022K0681)【抗菌剤】有機無機混合剤【加工部位・方法】エアフィルターに塗装 ●SIAAマークは ISO22196法により評価された結果に基づき、抗菌製品技術協議会ガイドラインで品質管理・情報公開された製品に表示されています。
※2:【試験機関】(一財)日本繊維製品品質技術センター、(一財)ボーケン品質評価機構【試験方法】ISO 21702【試験結果】24時間後に99%以上の低減率を確認(試験番号21KB030030-3、-4)(試験番号2022033394-1)(試験番号61022020092、61022020096)【抗ウイルス剤】有機無機混合剤【加工部位・方法】エアフィルターに塗装 ●抗ウイルス加工は、病気の治療や予防を目的とするものではありません。SIAAの安全性基準に適合しています。 ●SIAAマークはISO 210702法により評価された結果に基づき、抗菌製品技術協議会ガイドラインで品質管理・情報公開された製品に表示されています。
抗菌エアフィルター
Ag+(銀イオン)をコーティング。捕集したホコリに潜む菌の増殖を抑制※します。
フィルターの網目が細かく掃除しやすいので、お掃除ロボット非搭載機種も安心です。
●生えてしまったカビを除去する機能ではありません。
※:【試験機関】(一財)ボーケン品質評価機構【試験方法】JIS L 1902菌液吸収法【試験結果】2種類の菌で「コーティングなし」に対して99%以上減少していることを確認(試験番号25021000166-1、25021000195-1)
防汚・防カビ※1コーティング(送風ファン)
風を送り出す送風ファンにコーティングを施しています。
ホコリがつきにくく、汚れやカビが風と一緒にお部屋の中に広がるのを防ぎます。


防汚効果、防カビ効果※1、抗菌効果※2、帯電防止効果


※1:【試験機関】(一財)ボーケン品質評価機構【試験方法】JIS Z 2911【試験結果】かび抵抗性表示が、「コーティングなし」と比較して1段階以上、下回ったことを確認(試験番号20217071730-1)【防カビ剤ポジティブリスト】第JP0501054A0001R号、第JP0501003A0002M号、第JP0501055A0002T号を使用【加工部位・方法】送風ファンに塗装●防カビ試験は、SIAA指定方法にて実施しています。防カビ加工は、カビを死滅させるものではありません。使用条件によってはカビが発生する場合があります。SIAAの安全性基準に適合しています。
※2:【試験機関】(一財)ボーケン品質評価機構【試験方法】フィルム密着法に基づく【試験結果】試験片に試験菌を接種しフィルムを密着させ24時間後に菌が99%以上減少していることを確認。(試験は2種類のみの菌で実施)
空気清浄フィルター
0.3㎛の粒子を70%以上逃さずキャッチ。※
日頃気になる空気の汚れ(PM2.5・花粉)からお部屋を守ります。
●数値はフィルターの性能試験に基づく性能であり、実機の性能とは異なります。このフィルターでは0.3㎛未満の微小粒子状物質については、除去の確認ができておりません。また、空気中の有害物質のすべてを除去できるものではありません。PM2.5とは、2.5㎛以下の微小粒子状物質の総称です。
※:交換めやす:約2年
「日本アトピー協会推薦品」マークを取得


ナノイーX搭載エオリアはエアコンで初めて日本アトピー協会推薦品マークを取得。
ナノイーX搭載2018年以降モデル対象











